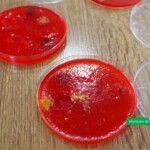

Agradecimiento del grupo de trabajo y familiares participantes de "La soñada"
[23-08-2021] Días pasados, el presidente municipal Dr. Carlos Weiss, recibió en su despacho una nota de agradecimiento de la asociación simple sin fines de lucro “La Soñada”.
En el escrito, el grupo de trabajo y familias que participan de dicha Asociación expresan su gratitud por el envío de maquinaria y tierra para arreglar el camino de acceso al predio donde realizan las actividades semanalmente permitiéndoles a las personas con discapacidad y familiares que los acompañan ingresar sin inconvenientes.
Agradecimiento de la Escuela Agrotécnica Nº73 “Alas Argentinas”
[24-08-2021] Días pasados el Presidente municipal Dr. Carlos Weiss recibió en su despacho una nota de agradecimiento de la Escuela Agrotécnica Nº73 “Alas Argentinas”.
En el escrito, la rectora de la institución, Prof. Sandra Acedo, expresa su gratitud por la donación de bancos de madera que fueron instalados en los entornos formativos pedagógicos, convirtiéndose en un aula abierta para el dictado de clases y anuncia que la comunidad educativa valora significativamente la visita junto a parte del personal de Gabinete la cual permitió dialogar y dar a conocer la oferta formativa de la institución a la que asisten adolescentes y jóvenes de Viale.
Resumen sesión ordinaria Nº 09/21 Honorable Concejo Deliberante
[23-08-2021] Durante la noche del miércoles 18 de agosto, se llevó a cabo la Sesión Ordinaria Nº09/21 del Honorable Concejo Deliberante.
A continuación se detallan los expedientes y proyectos tratados durante la jornada:
Se aprobaron:
- Expte: 6736)Proyecto de Ordenanza sobre creación del “Domicilio electrónico”.
- Expte: 6739) Nota de particular solicitando escrituración de un inmueble.
- Expte: 6744) Proyecto de Resolución declarando de “Interés Social y Cultural” la labor del artista local Nahuel BORRA.
- Expte: 6748) Proyecto de Resolución sobre reconocimiento y declaración de Interés Municipal a la labor del personal de salud de nuestra localidad: Hospital “Dr. Castilla Mira” y Centro de Salud “Ramón Carrillo”.
- Expte: 6751) Proyecto de Ordenanza adhiriendo al programa Nacional “Red de Mentores”.
- Expte: 6754) Proyecto de Resolución declarando de Interés Social y Cultural el Libro “Resurrección de las Campanas” de un conocido y destacado escritor de nuestra Provincia.
- Expte: 6755) Proyecto de Resoluciónde repudiando declaraciones de un funcionario.
- Expte: 6756) Proyecto de Resolución declarando de Interés Social y Cultural el programa radial “Caminata Sabatina”.
- Expte: 6758) Proyecto de Ordenanza sobre adhesión a la normativa Provincial relativa a la reestructuración de pasivos originados en empréstitos tomados.
- Expte: 6762) Nota del D.E.M., adjuntando el Decreto-D.E.M Nº 416/21 sobre aumento de haberes al personal Municipal (8.-%) a partir del mes de julio, incremento del Sueldo mínimo garantizado y demás cuestiones afines.
- Expte: 6764) Proyecto de Ordenanza sobre adhesión a la Ley Provincial Nº 9891 vinculada al desarrollo integral de las personas con discapacidad.
- Expte: 6773) Nota del D.E.M., adjuntando el Decreto-D.E.M Nº 441/21 sobre ingreso de fondos del Ministerio de Desarrollo de Entre Ríos haciendo un aporte de $188.121,30 para la adquisición de un monocultivador destinado al Parque Hortícola Municipal.
- Expte: 6774) Nota del D.E.M., adjuntando el Decreto-D.E.M Nº 442/21 sobre aumento de haberes al personal Municipal y salario mínimo garantizado.
Se pasaron a comisión:
- Expte: 6763) Proyecto de Resolución declarando de Interés Municipal a Libros de autoría del Sr. Humberto FOSSATI.
- Expte: 6766) Proyecto de Ordenanza sobre reglamentación del arbolado público.
- Expte: 6767) Proyecto de Ordenanza sobre creación en la órbita Municipal del área “discapacidad”.
- Expte: 6769) Proyecto de Ordenanza sobre digitalización de proyectos, convocatoria y demás temas afines.
- Expte: 6770) Proyecto de Resolución solicitando colocación de reductor de velocidad sobre Avda. “Pte. Alfonsín” antes de la intersección con Calle “Panutto”.
- Expte: 6771) Proyecto de Resolución solicitando colocación de reductor de velocidad sobre Calle “Ramírez” en lugar a determinar.
- Expte: 6772) Nota de particular solicitando se escriture a su nombre un inmueble.
Se archivó:
- Expte: 6768) Nota del D.E.M., contestando Pedido de Informe sobre préstamo de rodados Municipales a la Junta de Gobierno de “Aldea EIGENFELD”.
¡Alerta! la ANMAT prohibió un aceite de girasol considerado “ilegal”
[23-08-2021] El Área de Bromatología, Ambiente y Zoonosis alerta a los comercios y población en general que la Administración Nacional de Medicamentos, Alimentos y Tecnología Médica prohibió la elaboración, fraccionamiento y comercialización en todo el territorio nacional del producto: “Aceite de Girasol, marca Los Nietos, Contenido Neto 4.5 litros, RNE E/T 3104-28438/16, RNPA E/T 3104-28438/16”.
Según se indica, la prohibición se ha llevado adelante por carecer de autorización de establecimiento y de producto, y estar falsamente rotulado al consignar en su rotulo números de registro inexistentes, resultando ser un producto en consecuencia ilegal.
Por lo antes establecido, se recomienda a quienes hayan adquirido el producto mencionado o lo tenga en su poder, se abstenga de usarlo y realizar la denuncia pertinente en el caso de encontrarlos a la venta en algún comercio para proceder a su respectivo decomiso.
Segunda jornada de capacitación sobre manipulación de alimentos
[20-08-2021] Tal como estaba programado y bajo los protocolos establecidos, esta mañana se realizó una nueva capacitación en manipulación de alimentos en el salón de usos múltiples de la Caja de Jubilaciones y Pensiones del Municipio organizada desde el área de Bromatología, Zoonosis y Ambiente.
Dicha jornada estuvo a cargo del coordinador del área, Médico Veterinario Nerio Badaracco y personal a su cargo donde se remarcó que las buenas prácticas de manufactura son los procedimientos necesarios para lograr un alimento seguro para consumo, ya que nos permiten evitar los riesgos de contaminación, prevención de enfermedades transmitidas por alimentos y pérdidas económicas siendo fundamental aplicarlas en todos los eslabones de la cadena agroalimentaria.
Al finalizar la formación, los participantes ya con los contenidos y herramientas sobre higiene y las buenas prácticas alimentarias realizaron la evaluación correspondiente para la obtención del Carnet de Manipuladores que es emitido por el Instituto de Control de la Alimentación y Bromatología (ICAB) organismo provincial que tiene por objetivo principal resguardar la seguridad alimentaria en todas sus facetas, siendo depositario del cumplimiento del Código Alimentario Argentino al cual nuestra provincia adhiere.
Desde el Área se informa que el próximo grupo ya confirmado realizará su capacitación el próximo viernes, 3 de septiembre en el mismo horario y lugar que las jornadas anteriores con los participantes que reciban su confirmación en tanto aquellos que todavía no se han inscripto, podrán hacerlo en mesa de entrada del Municipio de lunes a viernes de 6:30 a 12:00 horas o en el NIDO de 6:30 a 12:00 y por la tarde de 15:30 a 19:30 horas.